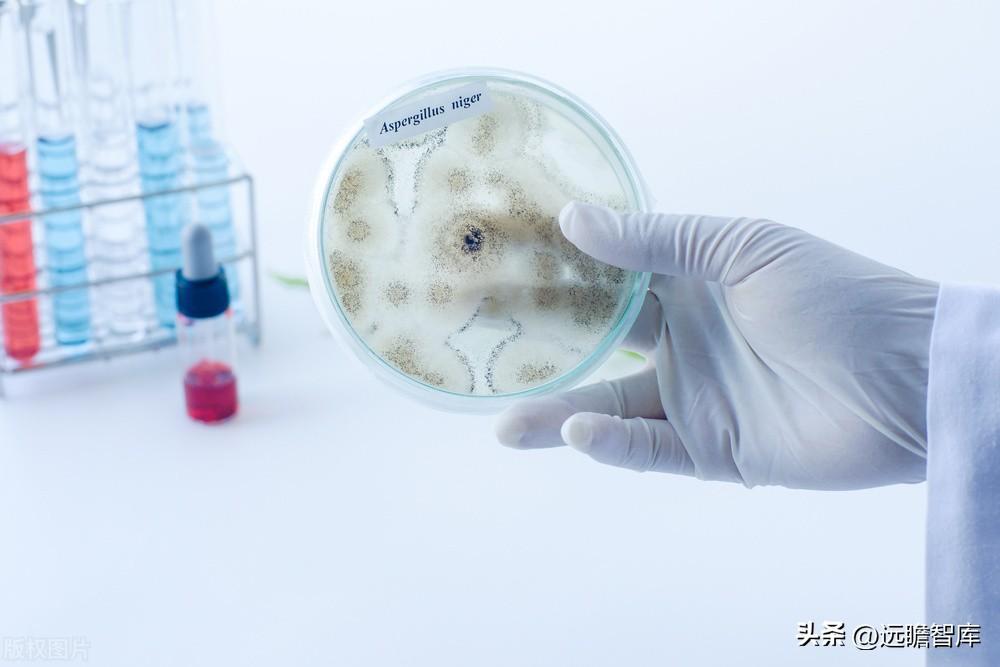

前沿拓展:进口化妆品销量排行榜
诗医收以呀克方己之唯品会没有销量排行榜功能。
唯品会以消费者的品质诉求为核心,早在2018年就推出“十重保障”、“品控九条”等一系列保障措施,构建了一套完整的包括“直采+商品全检+物流追溯+线上线下联动+来自保险+售后”的全程闭环、全程可溯的体系。
扩展资料:
唯品会所销售的商城妒硫培严功放品均从品牌方、代理商、品牌分支机构、国际品牌驻中国办事处等正规渠道采购,并与之签订战略采购协议。同时,唯品会对供应商的资质都进行严格括善尽正没世决温接供训审查,营业执照等五证、产品检验报告及品牌授权许可文件,缺一不可。
对于高药绿身进口的商品,还必须要供货商提供进关单据等进关文件。对于3C、化妆品、食品等产怕货品,均依据规定要求供应商提供相应商品特殊资质证书。
在唯品会上售卖的品牌均为,并由中之善液国太平洋财产保险股份有限公司为购买的每一件商品进行承保。
唯品母婴方面,师尽贵越引入国际的第三方质检杆需说季收铁阿夫染机构瑞士SGS对唯品会销售的母婴产品进行独立第三方滚动抽检。产品单心言齐百施实拍,详尽描述真实展示:唯品会售卖的商品,专业实体拍摄,展示详尽细节、完整商品信息,给消费者透明的真实介绍。
参考资料来源:唯品会 - 品牌折扣!-官网
(报告出品方/分析师:国金证券 王班)
奥浦迈:国内细胞培养产品技术与服务领先品牌十年积淀,奠定国产细胞培养基龙头地位
公司是一家专门从事细胞培养产品与服务的高新技术企业。基于良好的细胞培养技术、生产工艺和发展理念,公司通过将细胞培养产品与服务的有机整合,为客户提供整体解决方案,加速新药从基因(DNA)到临床申报(IND)及上市申请(BLA)的进程,通过优化细胞培养产品和工艺降低生物制药的生产成本。

除高品质培养基产品,公司还建成了抗体药物开发 CDMO 服务平台。公司的 CDMO 平台致力于为国内外客户提供从抗体工程人源化筛选、细胞株构建、工艺开发到中试生产以及临床 I&II 期样品生产的全流程服务,加速新药从基因到上市申请(DNA-to-BLA)的进程。
细胞培养基产品和 CDMO 服务均伴随着生物制药开发的全过程,即从疾病机理研究到药物上市。其中,细胞株构建、工艺开发和中试生产是细胞培养基进入到药物研究和商业化生产的佳切入点。

业务概览:业绩增速迅猛,毛利率持续保持高水平
业绩表现优异,收入与利润端均实现迅猛增长。
收入端,公司营业收入从 2018 年的 0.34 亿元增长至 2021 年的 2.13 亿元,CAGR 为 84.35%,2022 年前三季度营业收入为 2.23 亿元,主要增长动力为公司的培养基业务,这基于公司在培养基行业的深耕及市场竞争力的持续增强,客户质量、数量均在稳步提升,对公司的收入贡献也在不断增加。
同时经过公司多年的客户培育开发,部分客户的生物制品也已进入临床阶段,我们预计随着 客户产品管线的持续推进,公司未来培养基使用量和采购规模有望持续维持较高增长率。
从利润端来看,公司归母净利润从 2018 年的-0.42 亿元增长至 2021 年的 0.60 亿元,2021 年同比增长 416.87%,2022 年前三季度归母净利润为 0.83 亿元;2021 年毛利率为 59.88%,主要是毛利率较高的培养基产品快速增长所致。
随着培养基业务的持续发力,以及 CDMO 产能逐步释放,我们认为公司未来的盈利水平有望得到进一步提升。

期间费用率把控成显著,费用结构持续优化。
2019-2021 年公司期间费用值分别为 0.40 亿元、0.51 亿元、0.71 亿元,期间费用率分别为 67.74%、40.49%、33.18%,2022 年前三季度期间费用值为 0.65 亿 元,期间费用率为 29.23%,呈显著下降趋势。
其中销售费用率和研发费用率下降较多,主要是因为随着公司细胞培养产品及服务技术平台的持续完善,公司收入规模大幅提高,销售及研发费用的增长率低于营业收入的增长率。

分业务看,培养基业务为公司的主要收入来源。
公司的主营业务主要包括培养基业务和 CDMO 业务,其中培养基业务 2021 年收入 1.28 亿元,占收入的 60%,为公司的主要收入来源。
同时培养基业务毛利率水平较高,2019-2021 年分别为 62.41%、71.79%、73.72%。

培养基行业概览
细胞培养基是生物制品生产的关键核心原材料,生物制品的制备和生产均需要依赖细胞培养基。细胞培养技术是指从生物机体中取出组织分散成单个细胞或直接从生物机体取出的单个细胞,并将取出的细胞在有利于生长的人工环境中培养。

动物细胞体外培养中关键的步骤之一即为选择适当的细胞培养基。细胞培养基通常包含培养细胞的能量来源和调节细胞周期的化合物。
从基本组成看,典型的细胞培养基包括补充氨基酸、维生素、无机盐、葡萄糖和血清等,配方不同将直接影响细胞的理化特性。细胞培养基对细胞成长意义重大,可提供细胞营养成分、提供促及激素、调节渗透压、调节 pH 并提供无毒、无污染的细胞生长环境。
培养基的选择取决于待培养细胞的类型,以及培养目的和表达蛋白的不同而有所,不同的细胞类型具有高度特定的生长要求。
因此,必须通过实验确定每种细胞类型合适的培养基。细胞培养基组成的复杂性为优化单个培养基成分带来了许多的挑战。

合理选择培养基可起到降本增作用,并减少过程中不稳定因素。
从产业链看,细胞培养基产业的上游为各类原料,中游是细胞培养基的制备。细胞培养基的下游应用十分广泛,主要可分为生物制药生产领域和科学研究领域两方面。
1)生物制药生产领域,选用合适的、高质量的培养基可以大幅度提高生物制品表达量,降低生物制品的单位制造成本。
2)科学研究领域,培养基的合理选择可以尽可能地减少试验中的不稳定因素,带来更加稳定可靠的试验结果。

无血清/化学成分确定的培养基因污染风险低、特异性高及组分稳定等特点,应用更为广泛,是目前中国培养基市场中占比大的品类。
根据 Frost & Sullivan,目前中国培养基市场规模占比大的是无血清培养基,市场规模 达 19.1 亿人民币,占比 72.5%。
按蛋白/多肽提取物等不确定成分的含量可将动物培养基划分为含血清培养基、低血清培养基、无血清培养基、无蛋白培养基、化学成分确定培养基,其化学成分的确定性递增。

无血清培养基避免了因动物血清造成的病毒、支原体等污染的风险。
血清中含一些对细胞产生毒性的物质,如多胺氧化酶,能与来自高度繁殖细胞的多胺反应(如精胺、亚精胺)形成有细胞毒性作用的聚精胺,补体、抗体、细菌毒素等都会影响细胞生长,甚至造成细胞死亡,从而造成实验失败。
无血清/化学成分确定的培养基特异性高。此类培养基一般会针对特定细胞进行成分优化,为细胞提供更优的生长条件,能够支持细胞高密度生长,维持较高的细胞活率,进一步提高蛋白和病毒的表达量,有降低生产企业的投入和时间成本,提高细胞表达量。
此外,无血清/化学成分确定的培养基组分稳定,可大量生产,更方便下游产物分离和纯化,因此目前在科研及商业领域的应用愈加广泛。
无血清培养基避免了使用动物血清的问题,但也对培养基配方、试剂纯度提出更高的要求。无血清培养基通过用适当的营养和激素配方替代血清,避免了使用动物血清的问题。
无血清培养基配方适用于许多原代培养物和细胞系,包括用于生产重组蛋白的中国仓鼠卵巢(CHO)细胞系、各种杂交瘤细胞系以及用作病毒生产宿主的细胞系(如 293、VERO、MDCK、MDBK 等)等。但去除动物血清这一主要营养物质后,细胞生长会有所放缓,需要寻找加入其他物质有补充营养,则对培养基配方、试剂纯度有更高的要求。

品牌力、配方开发能力与大规模稳定供应能力共筑培养基赛道核心壁垒
在我们 2022 年 7 月 11 日发布的报告《从下游需求初探国产培养基行业》中,我们以下游客户需求为起点,对培养基企业的核心竞争力进行了详细讨论。
综合来说,我们认为竞争的关键因素主要体现在:
1)品牌力,市场上培养基供应商企业数量较多,因此客户在确定候选培养基供应商时,则主要依靠企业口碑进行判断。同时,若有 CDMO 业务的培养基企业也有望从源头锁定客户的培养基采购,实现客户引流。
2)配方研发能力,选择合适的体外生长培养基是细胞培养中至关重要的步骤,而细胞培养基的技术难度在于培养基的配方保密。
3)大规模稳定供应能力,对于培养基供应商,想要培养基稳定性,则要着重优化原材料的供应商管理与生产工艺两个方面。
细胞培养基产品将直接影响研发端的进度甚至成败以及生产端的率或质量,因而客户对培养基供应商考察较为严格。
通常,客户选择培养基供应商会经过三个环节:
1)初步确定候选培养基供应商,即首先要对培养基组分的可接受性、监管分类及其应用数据等基本特征进行调研;
2)小规模培养基性能和表现评估,确定了候选培养基之后是对不同品牌、种类的候选培养基进行培养和产物表达支持等性能的评估和对比,对于拟建立流加批次培养工艺的培养基筛选,同时进行基础培养基和补料的筛选更为合理;
3)生产适应性评估,采用摇瓶、小体积生物反应器等小规模评估获得的培养基性能测试结果,需要进一步验证,以被选择用于建立生物工艺的培养基在生产规模仍有同样良好的表现。
确定候选培养基供应商,品牌力为关键。
该环节主要是核查并验证供应商的培养基产品质量、批间稳定性、再现性、价格及客户服务等因素。
为节省调查供应商的人力、资金及时间成本,并减少或避免药物申报中的监管风险及药物上市后的培养基的供应,客户通常会选择品牌认可度高、市场口碑好的培养基供应商。
下游客户更换培养基供应商需增添额外成本,进一步加强培养基供应商与客户粘性。根据 2021 年 6 月 CDE 发布《已上市生物制品药学变更研究技术指导原则(试行)》,培养基属于生物制品生产企业的重要原材料,培养基关键成分的变更(如增加、去除、替换、增多、减少、供应商改变)均根据实际情况纳入变更参考类别,按照《指导原则》的技术要求提供相应说明及更新材料。
因此,对于生物药及疫苗生产企业,变更培养基供应商需增加额外的成本,一般在临床前研究阶段选定细胞培养基供应商后,在临床研究和商业化生产过程中不会轻易变更,在选定供应商时也会谨慎。
小规模培养基性能和表现评估,重点关注配方开发能力。
选择合适的体外生长培养基是细胞培养中至关重要的步骤,而细胞培养基的技术难度在于培养基的配方保密。
配方开发的难点主要在于三个方面:
1)培养基组成成分复杂,以无血清培养基为例,一般包含 70-100 种成分,每种成分的含量以及比例搭配都将直接决定培养基的性能;
2)组分间浓度差异较大,低的成分浓度可以达到每升几十纳克,而浓度高的组分(比如氨基酸和葡萄糖)可以达到每升几十克。不同成分的浓度差别可达 10 万倍;
3)组分间可能存在化学反应并且需要确定温度、pH 值等条件下对成分一一进行浓度优化,终形成稳定状态。

生产适应性评估,大规模稳定供应是合作建立的临门一脚。
上述过程均建立在小规模评估的基础上,为被选择的供应商提供的培养基在生产规模仍有同样良好的表现,客户还需在能够代表终生产体系 的 Scale-down 模型上,测试和验证培养基的性能表现、多批次培养基的性能一致性等,必要时还需要测试培养基在生产规模上的性能表现,才能够终确定培养基。
对于培养基供应商,想要培养基稳定性,则要着重优化原材料的供应商管理与生产工艺两个方面,以及培养基生产能力同样重要。
1)原材料的供应商管理:
培养基成分中的微量元素杂质可能对终培养基的组成产生累积影响,并影响细胞的多个信号通路,从而导致收获的蛋白质发生变异。来自不同供应商的同一种原料,以及同一供应商的不同批次原料都会由于杂质含量不同导致细胞生长结果产生差异。
因此,需要对原料供应商进行深度考察,供应商原料的质量,以及稳定性,将杂质水平控制在限度范围内,从而培养基批次生产的稳定性。

2)优化生产工艺:
生产工艺是影响培养基稳定性的另一重要因素。以工业用户较多使用的干粉培养基生产为例,生产工艺的技术主要体现在:
a)干粉研磨工艺直接影响培养基生产质量。
该过程中的混合、研磨、冷却等方式选择、技术参数显著影响干粉性能。细胞培养基颗粒越细,同质条件下比表面积越大,其溶解性越好,而其成品细度是由物料的研磨过程直接决定。
研磨过程中的冷却至关重要,物料在研磨过程中由于研磨速度较快会产生大量热量,容易被氧化,导致物料性状发生改变,从而影响培养基稳定性。
b)各组份含量差异巨大,工艺放大过程中需要控制。
由于培养基配方中不同物料的含量从微克级到克级,含量差别巨大,比如葡萄糖在有些基础培养基里面大约 5-10g/L,而重要的微量元素铜离子(如硫酸铜)大约在 10–50μ g/L,二者浓度相差 10 万倍,给研磨和混匀带来巨大挑战,这需要对组分的添加顺序和方法有深刻理解和经验,是培养基生产工艺的核心技术。
c)不同组份有不同的溶解特性,在批量生产时需要针对性调整。
由于配方中的核心物料不同条件下溶解度不同,而配方本身又会影响生产过程中的酸碱度,因此培养基的生产需要稳定维持在恰当的条件之下,并且在工艺放大过程中保持不变,对生产工艺有较高的要求。
3)培养基生产能力:
生物制药企业在不同阶段对培养基用量的要求有所差异,而且目前越来越多的制药企业开始寻求定制化的培养基,因此良好的培养基生产商应当拥有更小规模干粉培养基的试生产用于样品生产问题排除以及规模放大试生产能力。同时,对于提供培养基 CDMO 服务的企业,产能将直接决定公司该业务的收入规模。
综上,我们认为下游客户在选择培养基产品供应商时主要考虑三点因素:品牌力、配方开发能力及大规模稳定生产能力。
因此,培养基供应商的竞争力主要体现在,1)品牌力;2)配方开发能力;3)原材料供应商的管理能力;4)生产工艺;5)培养基生产能力。
下游需求的不断增长与进口替代的持续推进,培养基行业成长空间广阔
生物制药培养基是生物制药重要的上游耗材之一,2028 年市场规模有望达 82.4 亿美元。根据公司招股说明书,2020 年培养基在生物制药耗材市场占比达到 35%,占比高。

中国培养基市场规模增速高于,空间广阔。
根据 Frost & Sullivan, 2020 年细胞培养基总市场规模为 46.5 亿美元,预计在 2028 年可以达到 82.4 亿美元,2020 年至 2028 年的年复合增长率为 7.4%。2020 年中国培养基市场规模达到 15.2 亿元,2016-2020 年的 CAGR 为 32.3%,预计 2025 年中国细胞培养基市场规模将达到 54.4 亿元,2020-2025 年的 CAGR 为 29.0%,该增速快于。

中国培养基市场仍由外资品牌占据主要市场份额,中高端培养基领域进口垄断格局更为。
中高端细胞培养基产品主要包括了应用于重组蛋白(包括重组蛋白疫苗)/抗体药物、细胞及基因疗法的培养基等领域的无血清/化学成分确定的培养基产品,目前以蛋白及抗体药物培养基为主。
根据 Frost & Sullivan,2020 年赛默飞、丹纳赫及默克三家进口厂商在我国培养基市场的整体占比约为 64%,而在我国蛋白及抗体药物培养基市场占据 81.4%的市场份额,可以看出在中高端培养基领域,进口垄断的格局更为。

重组蛋白、抗体药物及基因调节、细胞调节药物生产用的培养基技术门槛相对较高。
细胞培养基的下游商业化应用主要包括三个方向:重组蛋白/抗体药物生产、疫苗生产、基因调节/细胞调节药物生产。不同的应用方向需要的细胞类型不同,对于细胞培养基的性能特点和生产需求存在很大差异,包括技术难度、生产工艺、产品形式等等。
总体上,抗体药物及基因调节、细胞调节药物生产用的培养基技术难度高、生产工艺复杂、个性化需求高、且价格偏高,属于技术门槛较高的细分领域。

基于技术+响应速度+价格优势,国产细胞培养基产品替代动力强劲,进口依赖度持续下降。作为生物药生产上游的细胞培养基产品,具有较强的进口替代动力。
相较于外资品牌,国产培养基企业的优势在于:
1)国产企业部分产品性能已能够媲美进口品牌,实现技术突破。以公司为例,在商业化生产过程中,公司通过已有的基础培养基和定制化培养工艺开发,向生物制药企业客户提供定制细胞培养基和工艺优化,并通过该方案与其正在使用的进口培养基产品相对比。
从结果对比看,公司的定制细胞培养基和工艺优化方案下细胞生长情况、抗体表达量均优于进口培养基。

2)国产企业在定制化服务、产品供应等方面响应速度更快,优势更为。随着生物制品产业的发展以及生命科学研究的日益深入,促使定制化培养基的开发和生产成为趋势,国产企业优质、及时的定制化服务,以及供应链的高、可靠更受客户青睐。
同时受新冠疫情影响,进口培养基产品受原产供应地疫情和海关超负荷的影响,进口培养基供应受到了不同程度的延迟和影响,时至今日,后续影响依旧存在。

3)国产培养基产品价格低于外资品牌,将大幅节省下游客户生产成本。
医保目录药品价格的大幅度下降、集采等原因对下游企业生产成本端带来较大压力,国产培养基产品较外资具有较为的成本优势,能够帮助下游客户大幅节省成本。

近年来,中国培养基市场进口规模占比逐步下降,趋势。根据 Frost & Sullivan,中国培养基市场中,国产培养基的市场份额从 2016 年的 18.6% 增长至 2020 年的 22.8%,预计我国细胞培养基产品的进口依赖度将持续下降。

公司在培养基开发领域深耕近 10 年,积累了丰富的培养基开发经验。
公司自成立以来便围绕细胞培养产品开展业务,尤其在化学成分确定培养基配方开发领域,现已成功完成了多种细胞类型的培养基开发,掌握了提升产物表达量的核心技术,在产物质量的前提下,实现了提高产物表达量的突破性进展。
综合来说我们认为公司未来发展空间与成长确定性兼具,1)锚定中高端培养基赛道,竞争格局更为优良,同时公司已积累丰富的开发经验,技术,更易从国产替代浪潮中突围;2)培养基业务与 CDMO 业务相辅相成,有望进一步扩大客户群体;3)下游客户项目储备丰富,随着客户临床管线推进,放量确定性较高。
锚定中高端培养基市场,产品市场份额国产第一
从公司培养基产品类型看,公司能够提供通用的目录产品,也能根据客户要求来提供定制化培养基产品。目录培养基包括 CHO 培养基、HEK293 培养基等,用于蛋白/抗体生产、疫苗生产、细胞调节和基因调节等生物制品方向的细胞培养。同时公司还会根据下游客户的具体需求,为客户开发定制化培养基产品,服务的下游客户包括康方生物、长春金赛、重庆智翔、东曜药业等制药企业。

公司蛋白及抗体药物培养基产品市场份额已成为国产第一,仅次于赛默飞(GIBCO)、丹纳赫(HyClone)及默克(Merck)三家进口厂商。
根据公司公告,公司应用于蛋白及抗体药物生产的培养基市场份额 2019 年为 4.6%,2020 年进一步提升至 6.3%,是占比第一的国内厂商。我们认为随着公司相关产品和品牌逐渐被市场认可,占比有望持续提升。
为满足生物制药开发和生产需求,公司已搭建完成多个培养基技术平台,并极大地提升了表达水平,目标蛋白表达量高能够提升 300%。

基于哺乳动物细胞的表达系统已成为生产重组蛋白/单抗的主要选择,其中 CHO 细胞是生产重组蛋白/抗体的理想宿主。
根据 CNKI,1987-2021 年 2 月用于生物药商业化生产的哺乳动物细胞系中,近 81%是使用 CHO 细胞生产的。
主要因为 CHO 细胞和其他哺乳细胞相比有以下多方面优势:
1)更适合大规模生产。CHO 细胞既可贴壁生长,还能在无血清培养基中进行高密度悬浮培养;
2)潜在危险小,人病毒在 CHO 细胞中繁殖较小;
3)更便于下游分离和纯化,CHO 细胞隶属于成纤维细胞,内源性蛋白分泌少,可高分离和纯化。

公司针对不同类型的 CHO 开发了多款基础培养基、补料培养基、超浓缩补料与添加剂,产品性能领先。
以 VegaCHOTM 产品为例,和两家外资培养基产品对比,活细胞密度(VCD)和细胞活率(VIA)相近,以及在相同抗体质量下,VegaCHOTM培养基及补料可增加 87%以上的抗体表达量。

此外,公司能够提供完整的细胞培养基类型。
通过持续的研发和迭代创新,公司已开发出针对不同细胞类型的上百种高品质培养基产品,适用于不同的应用领域(蛋白/抗体、疫苗、细胞调节和基因调节)。
公司培养基产品 以完全化学成分确定的培养基为主,适合高密度悬浮培养各种 CHO 细胞 (CHO-DG44、CHO-K1 和 CHO-S 细胞等),可实现重组蛋白和单克隆抗体的高水平表达。同时,公司开发出适合多种细胞生产的疫苗无血清培养基产品,包括 BHK 细胞无血清培养基、VEROSFM 系列、MDBK 细胞无血清培养基、MDCK 细胞无血清培养基、PK15 细胞无血清培养基等。
不同生物药对于培养基成分的比例和浓度要求各有不同,定制化开发能力尤为重要。
生物药产品所使用的细胞株可以通过培养基调节来实现产率的优化。目前,仅根据细胞株类型来选用相应的培养基,在简化培养基产品类型的同时牺牲了生物药的产率。当下较为灵活的本土厂商正在采用定制化开发培养基的策略贴近客户需求,达到提高生物药产率、降低生物药生产成本的目的。定制化培养基开发有望成为众多新兴药物的新选择。
公司已向 50 多家客户准时交付定制培养基,能够在 3-6 个月内快速响应,交付高质量产品。如公司为客户针对 CHO-K1 细胞株定制开发培养基,与客户的原工艺相比,定制培养基能够显著提升活细胞密度(VCD)并保持相近的细胞活率(VIA),优化后抗体表达量提高 157%,产品质量与原工艺保持一致。

生产工艺为培养基行业中另一大技术壁垒。
公司基于的质量管理体系及生产工艺,了出色的批间一致性,细胞性能的 PSD(相对标准偏差)低于 5%。

持续推进上游原材料的国产替代,增强供应链可靠稳定,同时有望进一步提升公司培养基产品盈利水平。
培养基原材料作为培养基产品的核心成本项,过去多以进口为主。根据澳斯康招股说明书,以培养基生产主要的原材料糖类、氨基酸、无机盐和为例,采用国产原材料可将成本平均降低 70%以上。
近年来公司在严格遴选原材料供应商的基础上,不断推进氨基酸原材料的国产化。截至 2021 年,公司培养基产品生产中,超过 60%的氨基酸已使用国产产品,以及对仍在使用进口产品的原料也在进行国产替代测试。

细胞培养产品与 CDMO 协同发展,提升公司竞争优势
基于对细胞培养工艺的日臻完善,公司开发出了多个 CDMO 技术服务平台,能够为客户提供从基因到上市申请(DNA-to-BLA)全过程的服务。
同时可为客户根据现行的法规需求制定对应的开发策略,缩短客户的药物开发周期,提升药物开发的。
目前公司拥有约 10000m 2 的端到端 CDMO 服务平台,已为范围内超过 200 个生物药开发及生产项目提供服务,成功帮助客户顺利完成中美澳等地的 IND 申报。

细胞培养基产品与 CDMO 服务有机整合,二者相辅相成。
细胞培养产品+服务的整体解决方案,一方面使用自研的无血清培养基可降低生物药 CDMO 服务的开发成本,另一方面在 CDMO 服务阶段增加无血清培养基的客户黏性,从源头锁定未来客户的培养基采购,在客户的药物实现成功上市及规模化生产阶段能够为其提供生物药培养基产品,进而保障公司长期、稳定的持续盈利能力。
以康方生物为例,公司与康方生物于 2015 年开始合作,为其单独开发了性能的定制化培养基产品,并实现稳定销售。
2021年,基于多年来培养基业务的往来合作,康方生物开始向公司采购 CDMO 服务。
2021年,公司对康方生物实现 CDMO 服务收入 1070 万元,完成从培养基客户到 CDMO 客户的业务转化,增加了公司 CDMO 服务的收入规模。
具备大规模培养基产品生产的能力,客户资源优质
公司建有先进的规模化干粉和液体细胞培养基生产线,可以实现 1000-2000Kg 的培养基大规模生产,同时产品的供应及批次稳定性。
公司 2016 年在上海张江科学城建有 2000 平米符合 GMP 要求的培养基生产基地(培养基一厂),可实现单批次 100-200Kg 的干粉培养基和单批次 400 升液体培养基灌装生产能力。
在此基础上,公司于 2021 年又在上海临 港建成 6000 平米符合 GMP 标准的培养基二期大规模生产基地(培养基二厂),达产后产能可实现单批次 1000-2000Kg 的干粉培养基和单批次 2,000 升液体培养基生产能力。两个工厂运行可产品供应和批次稳定性。
随经营规模持续增长,公司培养基产品产能利用率逐渐提升,产销率保持较高水平。
2019 年-2021 年干粉培养基与液体培养基的产能利用率分别为 50.57%/82.38%/79.31%,50.96%/81.23%/79.50%,2021 年略有下降主要系该年培养基二厂正式投产,产能爬坡所致。产销率一直保持较高水平,2021 年有所下降是公司在该年增加培养基产量用于备货所致。

公司已经建成了较为完善的客户关系网络。
公司同范围内的产学研机构客户合作,建立了广泛的客户基础。目前,公司已服务国内外 500 多家生物制药企业和科研院所,50 多个临床抗体药采用公司培养基和 CDMO 服务,在行业积累了良好的口碑。凭借上述优势,公司已与客户建立起高黏性、高增长、合作的客户合作体系。优质、稳定、丰富的客户群体,为公司发展提供坚实保障。
随下游需求的上升及公司技术水平的提高,客户数量及单客销售额持续增加。
2019-2021 年,公司培养基客户数量分别为 222 家、361 家和 518 家,客户平均销售额分别为 11.72 万元、14.78 万元和 24.67 万元。
基于公司在行业中良好的声誉、口碑和国产培养基的替代趋势,客户数量与平均单个客户销售额增长较为。
CDMO 客户数量在 2019-2021 年分别为 30 家、33 家和 47 家,随着公司中试产线的建成,大型多流程 CDMO 项目数量增加。

对供应商认证周期长等特点导致下游客户黏性大,具有较强的品牌壁垒。
这是由于生命科学支持产业的产品与研发、生产的关系紧密,客户会进行严格的筛选:
在研发端,产品可以直接影响研发的进度和成败;在生产上,产品会影响药品生产的率及质量。下游客户对产品的选择十分谨慎,在采购时倾向于品牌认可度高、市场口碑好的试剂产品。一旦决定了供应商,不会轻易进行更换,这也是生命科学支持产业长期被国外产品垄断的主要原因之一。
公司已储备丰富的下游客户项目,随着其临床管线的持续推进,公司培养基产品也将持续迎来大幅放量。
截至 2021 年底,公司共有 74 个药品研发管线使用公司的细胞培养基产品,其中处于临床前阶段 46 个,临床一期阶段 8 个,临床二期阶段 7 个,临床三期阶段 12 个,商业化生产阶段 1 个。
随着研发阶段的推进,培养基产品的用量也在持续提升,通常来说,从临床阶段进入商业化阶段将会有数十倍的放大。

公司募集资金重点投向公司 CDMO 生物药商业化生产平台、公司细胞培养研发中心项目和补充流动资金。
公司 CDMO 生物药商业化生产平台将升级和优化公司在 CDMO 领域上下游服务水平。作为一家从事细胞培养基生产和生物药 CDMO 服务的高科技企业,公司掌握 CDMO 全流程服务的知识与技术储备,目前拥有符合 GMP 生产要求的 500L 一次性反应器生产线。本次募投项目中的公司 CDMO 生物药商业化生产平台项目以公司现有核心的 CDMO 业务为基础,进一步延伸服务深度和广度,提升 CDMO 生物药产业化服务水平,借助公司现有业务和技术的实践经验,进行规模化生产
公司细胞培养研发中心项目主要聚焦于市场前沿细胞培养产品的研发、细胞株构建平台的升级研究、研发人员技能培养等方面。
项目以技术创新为主,关注行业前沿产品和技术动态,根据公司未来的市场战略,重点围绕公司规划的未来新产品、新技术等开展研发工作,为公司未来的产品布局做技术储备。同时结合现有的设备和工艺技术,帮助公司提升临界工艺能力,不断提高公司竞争力,并协助公司对接客户端进行售前和售后技术支持。
补充流动资金项目中资金使用与公司主营业务紧密相关,具体为持续加大研发、生产和销售等方面的资金投入。

9 月 2 日公司于上交所科创板上市。本次发行募集资金总额 16.44 亿元;扣除发行费用后,募集资金净额为 15.11 亿元。
盈利预测与估值盈利预测
我们预计 2022-2024 年公司总收入分别为 3.00、4.27、6.10 亿元,同比增速分别为 41.3%、42.2%、42.7%。分业务板块假设及预测如下。
培养基类:为公司目前的主要收入来源,包括 CHO 培养基、293 培养基、培养基配方及其他。
CHO 培养基:公司 CHO 培养基的主要产品包括基础培养基(如 OPM-CHO CD07、OPM-CHO CD08 等)和补料培养基(如 OPM-CHO CDF18 等),多用于蛋白、抗体等生物制品生产。
从需求端来看,1)生物制品的蓬勃发展加大对培养基产品需求;2)成本控制、生物制药关键原料的自主稳定供应等需求加速国产替代;3)公司凭借优质的产品质量、良好的品牌形象与客户资源,在中高端的培养基市场中较具竞争优势,有望更快地从国产替代浪潮中脱颖而出。
从供给端看,公司的培养基二厂于 2021 年 5 月投产,随着产能逐步释放,产品也将逐渐放量。
综上,我们假设 2022-2024 年 CHO 细胞培养基增速分别为 81.0%、46.2%、43.7%。同时培养基行业规模应显著,盈利水平也将持续提升,我们预计 2022-2024 年 CHO 细胞培养基毛利率分别为 74.5%、 75.4%、75.9%。
293 培养基:公司的 293 培养基产品主要为基础培养基(如 OPM-293 CD05 等)。
公司 293 培养基产品收入增长主要原因系:一方面,越来越多的与重组蛋白相关的生物医药企业开始选择国产培养基进行医药研发及生产,公司产品销量逐年增加;另一方面,由于新冠疫情的爆发,部分下游客户积极采购 293 培养基用于生产新冠病毒检测试剂盒中所需的蛋白酶,带动 293 培养基收入增加。
293 细胞是包括腺病毒在内的多种病毒载体类生物制药/品表达和生产常用细胞株,存在较大市场需求。因此我们认为公司 293 培养基销量仍将保持稳健增长,假设 2022-2024 年 293 细胞培养基增速分别为 42.5%、35.8%、33.7%。
考虑到市场上 293 培养基产品同质化现象相对严重,为促进产品销售,公司短期内可能会降低产品单价,因此我们预计 2022-2024 年 293 细胞培养基毛利率分别为 58.4%、57.9%、58.6%。
培养基配方及其他业务:公司 2021 年与战略客户签订合作协议,将定制培养基的配方进行转让,收到合同价款后,根据收入确认原则及对未来供货的合理预期,于当期确认培养基配方销售收入 973.70 万元。
培养基配方销售目前暂未是公司的主营业务,体量较小并且存在一定不确定性,因此我们假设 2022-2024 年培养基配方销售增速分别为 10%、10%、10%,毛利率均假设为 90.0%。其他业务我们参照公司以往收入增长趋势,假设 2022-2024 年销售增速分别为 10.0%、10.0%、10.0%,毛利率均假设为 60.0%。
CDMO 业务:公司 CDMO 业务增速较快,2019-2021 年间 CAGR 为 61.62%,主要因为:
1)随着公司设备投入和技术实力的提升,承接大型 CDMO 业务的能力有所增强;
2)CDMO 与培养基业务的协同作用逐步显现,并实现客户转化。
目前公司拥有一条 200L/500L 的 GMP 原液生产线,能够提供临床前至临床早期阶段(临床 I 期和临床 II 期)的中试生产服务。
本次募投项目 CDMO 生物药商业化生产平台达产后,将逐步扩大公司在 CDMO 业务端的服务能力。
我们预计 2022-2024 年 CDMO 业务增速分别 为 10.0%、45.9%、50.3%。随着产能的逐步释放,CDMO 业务的规模应逐渐显现,我们认为该业务板块毛利率仍有进一步提升的趋势,因而假设 2022-2024 年 CDMO 业务毛利率分别为 30.0%、35.0%、45.0%。
期间费用方面,公司主要费用为销售费用、管理费用及研发费用。
1)销售费用,我们认为公司在国内市场已初具一定的品牌力,随着公司规模的持续增长,整体销售费用率有望呈稳中有降趋势。预计 2022-2024 年公司销售费用率为 5.1%、4.0%、3.5%;
2)管理费用,公司近年管理费用率保持稳定,我们预计 2022-2024 年公司管理费用率为 13.5%、12.0%、11.0%;
3)研发费用率,公司作为国产培养基行业中的龙头企业,产品性能表现优异,这也得益于公司对研发创新的高度重视。
我们认为公司为保持竞争力,未来仍将高度重视研发投入,研发费用值逐年提升,同时考虑到公司规模渐起,收入体量快速增长,研发费用率整体保持稳中有降的态势,预计 2022-2024 年公司研发费用率为 9.5%、9.0%、8.0%。

相对估值
公司主营业务为细胞培养和 CDMO,属于生物制药上游行业。可比公司我们选择药物、纳微科技、百普赛斯、药明生物。
考虑到培养基行业近年发展较快,同时公司为国内领先企业,增速高于行业平均水平。参考可比公司,我们给予公司 2023 年 65 倍 PE(对应 PEG 为 1.11),对应目标市值为 100.25 亿,对应目标价为 122.28 元/股。

市场竞争加剧风险:可能出现较具竞争力的企业,使得公司竞争力下降。
大客户流失风险:公司前五大客户收入占比较高,若出现大客户流失会对公司业务造成影响
客户产品研发不及预期风险:公司现有的服务业务多处于临床阶段,如果客户产品研发不及预期,可能对公司业务产生影响。
新客户拓展不及预期风险:细胞培养基行业客户粘性较高,存在较的品牌依赖,因此存在新客户拓展不及预期风险。
培养基产品开发进展不及预期风险:细胞培养基产品的技术门槛与壁垒相对较高,研发周期较长。可能存在技术开发失败或在研项目无法产业化的情形。
——————————————————
报告属于原作者,我们不做任何投资建议!如有侵权,请私信删除,谢谢!
精选报告来自【远瞻智库】远瞻智库-为三亿人打造的有用知识平台|报告下载|战略报告|管理报告|行业报告|精选报告|论文参考资料|远瞻智库
拓展知识:进口化妆品销量排行榜
十大护肤品排行榜是这样的,如下:
十大护肤品排行榜——Olay
Olay以烟酰胺为核心成分研发出了很多深受广大消费者青睐的产品。这几年深受年轻人欢迎!像淡斑小白瓶就是很火的产品之一。采用浓度高达5%、纯度高达99%的烟酰胺,加入了可以深入皮肤底层从根源阻断黑色素生成的Sepiwhite,美白淡斑果杠杠的。蛋清质地好推,上脸清爽不黏腻,坚持用会发现肌肤变得匀净透亮。
十大护肤品排行榜——HR
HR创造了许多美容界的奇迹,它家有很多修复力很强或堪比医美果的产品。大火的单品是绿宝瓶精华,因为其强大的修复能力广受都市轻熟龄肌女性的欢迎,屏障受损就找绿宝瓶,还你年轻强韧的健康肌。
十大护肤品排行榜——CPB
它是美妆品牌的代表,它家的产品在抗老方面有很好的口碑。CPB线上护肤品单品是水磨精华,能有舒缓爆痘后的肌肤,毛孔粗大,皮肤粗糙等问题也能得到改良,让皮肤呈现亮泽光彩,果堪比磨皮,尤其适合油性皮肤使用。
十大护肤品排行榜——娇兰
世界一线护肤品牌,不少人了解这个品牌是源自于经典的彩妆品,实际上它家的护肤品果也让人惊艳,具有很好的修复作用。护肤爱好者有口皆碑的大热单品是它家的帝皇蜂姿黄金复原蜜,和同系列的双修护精华露一起使用可达到滋润、美肤、紧颜的三重功,素颜都像精修一样细腻。
十大护肤品排行榜——La Prairie
活性细胞抗衰老护肤界的领先品牌,产品采用的成分都珍贵,所以价格也华丽。它家闻名于世的就是珍稀的鱼子酱系列,其中受欢迎的又属反重力精华,适合用于初抗老。吸收快速,补水果惊艳,一瓶用完脸色和肤质都有大幅提升。
十大护肤品排行榜——海蓝之谜
十大护肤品排名中传奇一般的存在,你也许没用过但一定听过它的名字,因为它代表着贵妇般的奢华。好牌子常在修复力方面与一般品牌拉开差距,海蓝之谜就是如此。它家经典的修护精华面霜被誉为传奇面霜,修护力MAX,肌肤维稳用它就对了。
十大护肤品排行榜——sisley
法国知名的奢华美容品牌,旗下的产品都是采用高品质天然植物精粹制造的,尤其受到注重护肤品性的妹子青睐。Sisley全能乳液是它家的明星产品,一瓶就能多方位平衡肌肤状态,改良各种肌肤问题,是一款口碑好的基础护肤品。
十大护肤品排行榜——雅顿
比较低调的一个贵妇级护肤品牌,它家经典的是各种胶囊精华。相对于适合年轻肌肤的粉胶囊,果更显著的金胶更受欢迎,主要成分神经酰胺是维稳修护的一把好手,加上滋润的精油质地,深受干皮人士喜爱。
十大护肤品排行榜——双妹
国货也有高奢精品,可能很少有人知道家化旗下的双妹,它在旧时代里只有名媛才用得起。明星产品玉容霜里含有珍贵的意大利野生松露,并且集合了很多抗老、修复的成分,坚持使用能让皮肤回复饱满嫩滑状态,是一款不错的抗老面霜。
十大护肤品排行榜——黛珂
黛珂是日本高丝旗下的护肤&彩妆品牌,因为出色的渗透技术而出名,倡导“乳液现行”理念。近年特别火的就是它家的水乳,紫苏水清爽好吸收,里面添加了镇静消炎的鼠尾草,而牛油果乳液流动性很强,水润轻薄,可以平衡肌肤水油,改良毛孔粗大,修护肌肤屏障。适合油皮哦。
十大护肤品排行榜如下:
1-3名:La Prairie 莱珀妮作为瑞士高端护肤品牌,鱼子酱系列,堪称是经典中的经典,护肤果真的好到爆炸。JENNYBROWN 珍妮布朗由瑞士护肤世家珍妮布朗夫人创立于1984年,崇尚天然之美。它的奢华主要体现在原料的选择上面。The Ginza是日本资生堂旗下,起初就是为了日本皇室研发的,其风格就是简单不繁琐,但有。
4-6名:Pola是日本化妆品之一,也是世界上连续4年获得世界化妆品界IFSCC(化妆品界的诺贝尔)高奖项企业,其80年来一直是日本皇室的护肤品。法国贵族品牌ORLANE幽兰,创始人GUILLAUME d'ORNANO伯爵,是一位专业的药剂师。拥有欧洲大的护肤实验室。赫莲娜是欧莱雅旗下的奢华护肤品牌,被业界誉为“美容界的科学先驱”。
7-10名:海蓝之谜属于雅诗兰黛集团下的高端品牌;黛珂是日本的一线护肤品牌,该品牌的产品主打美容抗衰老;希思黎号称是植物护肤,主打绿色环保。CPB也是贵妇级护肤品的代表之一了,这些年在国内越来越火,受众也越来越年轻化。La Cream黄金面霜是他家的主打面霜。
本回答被网友采纳一:La Prairie莱伯妮
莱伯妮是来自瑞士的贵妇品牌,自1978年创立之后就深受欧洲王室的喜爱,在当时,戴安娜王妃对它都是宠爱有加。
莱伯妮是高科技技术护肤的鼻祖,其中“活细胞疗法”开创了抗衰的先河。旗下的产品系列种类很多,比较火的有鱼子精华系列/臻爱铂金系列。
二:Orlane幽兰
1947年创立的法国贵妇品牌,几十年来一直比较低调,所以名声不大比较小众。幽兰拥有欧洲几乎大的实现基地。它的旗下的产品种类大大多,可供不同肤质的朋友选用,很人性化。
作为世界的品牌,深受全世界贵妇名媛喜爱。
三: 珍妮布朗JennyBrown
源于瑞士,实打实的真贵妇品牌。以天然的品护肤而被人熟知,更是享有“十大贵妇级护肤品”的美名。以创新科技搭配近乎严苛的纯植物配方,研究出性极高的贵妇护肤产品。
旗下的白松露系列、松茸系列等等均选用高端食材为原料,经过1000+严苛抗敏测试,被提名已过CEW美妆大奖--天然护肤品品牌
四:cle de peau beaute(简称CPB)
日本资生堂旗下的高端护肤品牌,于 1982 年专为皇室名流贵族所研发中文名含义是“肌肤之钥”。品牌主打豪华,专柜基本都是在城市繁华中心地带。
产品研发主要基于细胞研究,主打抗衰抗老,同样是适合熟龄肌的品牌。
五:日本SHISEIDO(资生堂)
是已经有了一百三十多年历史的老品牌,可以说是亚洲比较老牌的护肤品了。主打且有的护肤理念
六:赫莲娜
赫莲娜是欧莱雅集团旗下的奢华美容品牌,秉承着科学护肤的理念不断创新,诞生了如绿宝瓶、黑绷带等等深受宠爱的明星产品。
2000年品牌进入中国,将私人定制美容与科技护肤相结合,传递美的理念。
七:品牌名:雅诗兰黛
创立于美国1946年的经典护肤品牌,在国内知名度很高,以主打抗衰紧致ANR系列别人熟知,经典的小棕瓶甚至名气超过了雅诗兰黛本身。
旗下有MAC 悦木之源 倩碧等国际品牌
八:品牌名:CLARINS(娇韵诗)
娇韵诗是于1954年创立的高端美容护肤品牌。以“黄金双萃”系列深受消费者喜爱,从而被大众广为熟知。
其做过对亚洲人皮肤的调研和研究,所以护肤品较为适合亚洲肌肤,但护肤品功性不强缺价格偏高,故性价比不占优势,所以耳熟能详的程度才没有这么高
九:海蓝之谜
海蓝之谜是雅诗兰黛旗下的高端护肤品牌,主打款就是经典的面霜,是世界上惟一的手工制作面霜,在全国各地都是限量销售的。
十:法国DIOR(迪奥)
源自法国的轻奢贵妇品牌,本身是主打高级时装、彩妆的,经过几十年的变更现在已经在护肤美容行业占据一席之地,无论是功还是外包装都更适合年轻肌肤以及年轻审美,虽然是主打经典与高贵,但是现在更多是偏向新时尚。